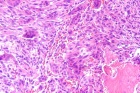
Zoom image: Cell stain

Case 2
M.C. – 29 year old white male with five month history of left hand pain.
Physical exam demonstrates tenderness to palpation overlying base of 3rd metacarpal, left hand NVI.
Upcoming Events
Import medical school events to your Exchange, Gmail, iPhone or iPod calendar. Customize your calendar by selecting different event categories and receive automatic reminders of the school events that matter most to you.